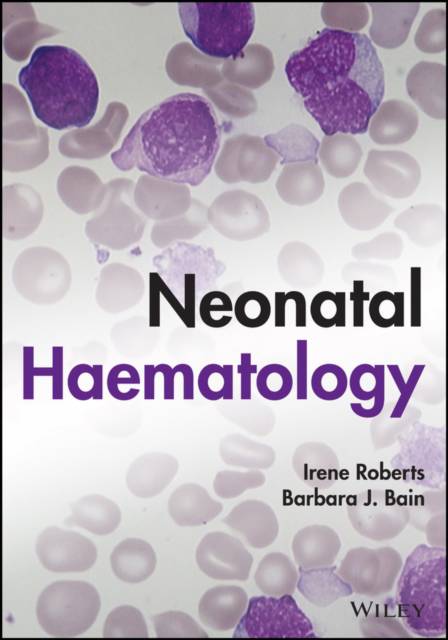

- Afhalen na 1 uur in een winkel met voorraad
- Gratis thuislevering in België vanaf € 30
- Ruim aanbod met 7 miljoen producten
- Afhalen na 1 uur in een winkel met voorraad
- Gratis thuislevering in België vanaf € 30
- Ruim aanbod met 7 miljoen producten
Omschrijving
This unique handbook contains comprehensive coverage of neonatal haematology and aids diagnosis via high-quality images, diagnostic algorithms, case studies, and tables. With illustrations accompanying the diagnosis at each stage and clear explanations provided throughout, the book is ideal for trainees and experts alike.
Authored by two of the world's leading haematologists, Professor Irene Roberts and Professor Barbara Bain, this book provides a depth of knowledge that is unequalled in other texts. To aid in reader comprehension, it is neatly organised by clinical problems and covers sample topics such as:
- Red cells: morphology, membrane, enzymes, and changes over the first 4 weeks of life
- Haemolytic anaemias: causes of neonatal haemolysis, diagnostic clues, and immune haemolysis (haemolytic disease of the newborn)
- Neonatal anaemia due to blood loss: causes of blood loss, diagnostic clues, feto-maternal haemorrhage, and twin-to-twin transfusion
- Haematological signs of neonatal infection: causes of neutrophil left shift, leucoerythroblastosis, and toxic granulation
Paediatric haematologists, consultant haematologists, and trainees in haematology can use the succinct, well-written content in this book as a useful helping hand during consultation. Biomedical scientists will also value the work as a laboratory reference.
Specificaties
Betrokkenen
- Auteur(s):
- Uitgeverij:
Inhoud
- Aantal bladzijden:
- 304
- Taal:
- Engels
Eigenschappen
- Productcode (EAN):
- 9781119371588
- Verschijningsdatum:
- 6/09/2022
- Uitvoering:
- Hardcover
- Formaat:
- Genaaid
- Afmetingen:
- 170 mm x 244 mm
- Gewicht:
- 725 g

Alleen bij Standaard Boekhandel
Beoordelingen
We publiceren alleen reviews die voldoen aan de voorwaarden voor reviews. Bekijk onze voorwaarden voor reviews.